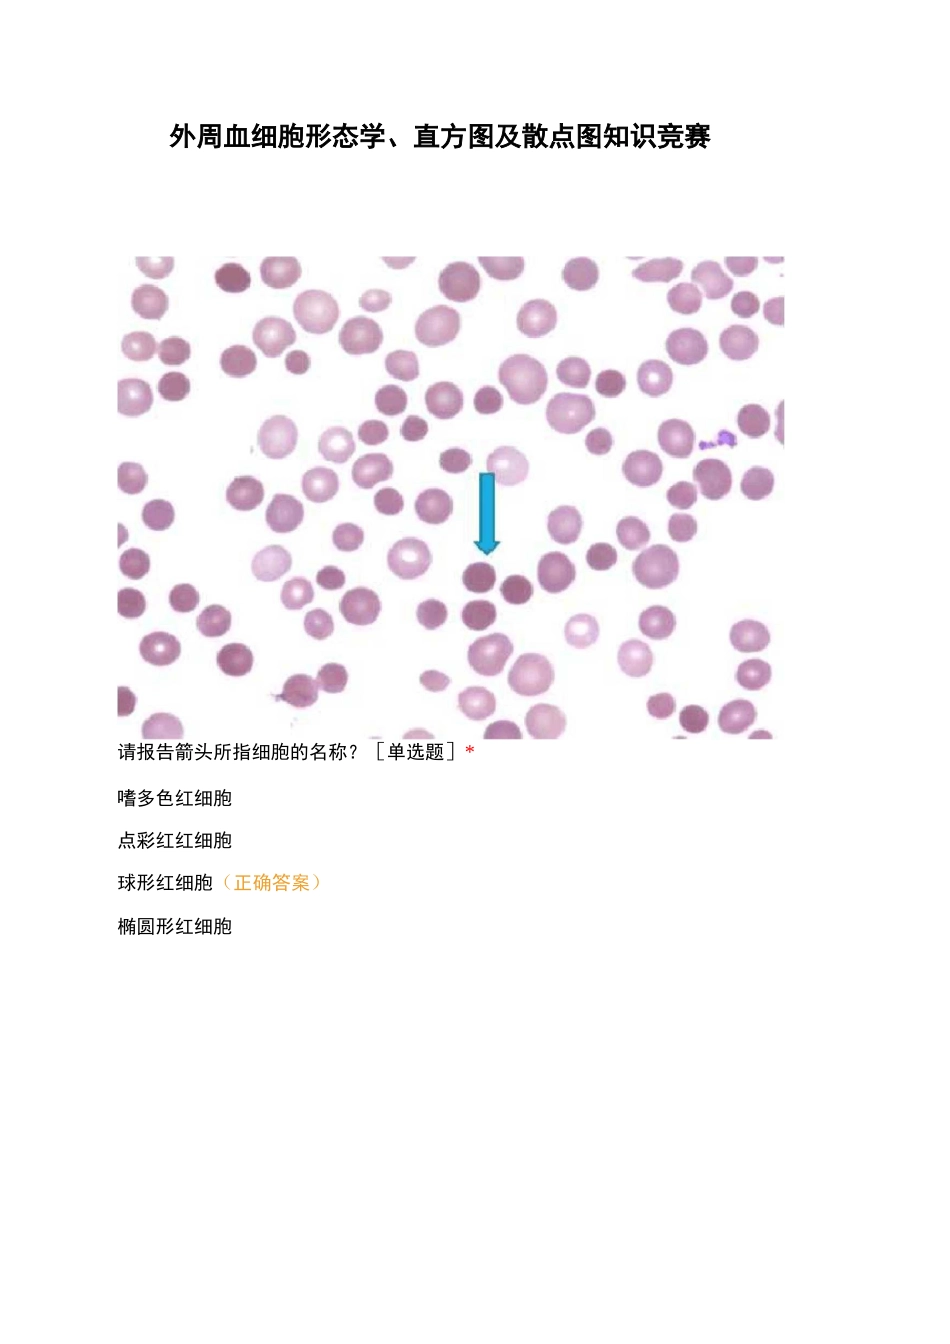

外周血细胞形态学、直方图及散点图知识竞赛请报告箭头所指细胞的名称
[单选题]*嗜多色红细胞点彩红红细胞球形红细胞(正确答案)椭圆形红细胞2
请报告箭头 a 所指细胞的名称
[单选题]*中性分叶核粒细胞中性中幼粒细胞嗜酸性粒细胞(正确答案)嗜碱性粒细胞3
请报告箭头所指红细胞内结构的名称
[单选题]*含铁血黄素颗粒豪乔氏小体(正确答案)帕彭海姆氏小体Heinzbody4
请报告箭头所指细胞的名称
[单选题]*中性分叶核粒细胞含中毒颗粒的中性粒细胞嗜碱性粒细胞(正确答案)嗜酸性粒细胞5
请报告箭头所指细胞内结构的名称
[单选题]*cabotring(正确答案)Howell-JollybodyauerbodyPappenheimerbody请报告箭头所指细胞的名称
[单选题]*成熟单核细胞浆细胞成熟淋巴细胞异型淋巴细胞(正确答案)请报告箭头所指细胞的名称
[单选题]*嗜多色红细胞(正确答案)网织红细胞巨红细胞椭圆形红细胞8
请报告片中箭头所指的细胞是
[单选题]*皱缩红细胞棘形红细胞裂红细胞(正确答案)泪滴形红细胞9
请报告箭头所指细胞的名称
[单选题]*巨多分叶核粒细胞(正确答案)杆状核粒细胞凋亡细胞退化细胞请报告箭头所指细胞的名称
[单选题]*嗜多色红细胞点彩红细胞椭圆形红细胞靶形红细胞(正确答案)12
请报告箭头所指细胞的名称
(BM)[单选题]*成熟单核细胞巨(中性)杆状核粒细胞(正确答案)中性晚幼粒细胞中性分叶核粒细胞请报告箭头所指细胞的名称
[单选题]*篮细胞晚幼红细胞中幼红细胞巨大血小板(正确答案)请报告箭头所指细胞的名称
[单选题]*早幼粒细胞中性中幼粒细胞(正确答案)中性晚幼粒细胞成熟单核细胞14
请报告箭头所指细胞的名称
[单选题]*单核细胞(正确答案)中性中幼粒细胞中性晚幼粒细胞中性杆状核细胞16
请报告箭头所指细胞的名称
[单选题]*淋巴细胞浆